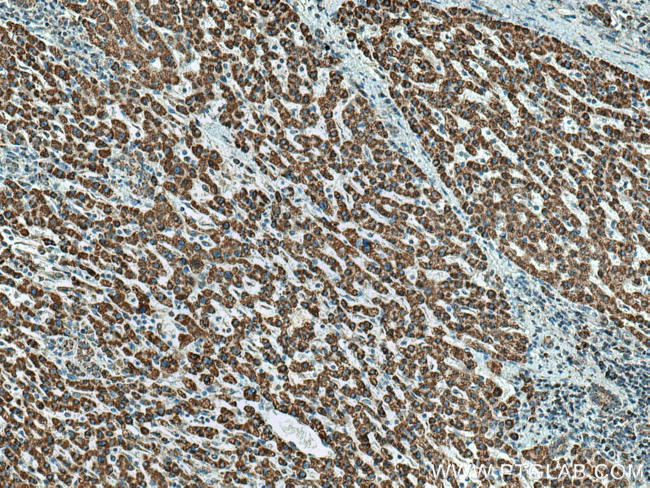
HIBADH Antibody in Immunohistochemistry (Paraffin) (IHC (P))

Search
Proteintech
HIBADH Polyclonal Antibody
{{$productOrderCtrl.translations['antibody.pdp.commerceCard.promotion.promotions']}}
{{$productOrderCtrl.translations['antibody.pdp.commerceCard.promotion.viewpromo']}}
{{$productOrderCtrl.translations['antibody.pdp.commerceCard.promotion.promocode']}}: {{promo.promoCode}} {{promo.promoTitle}} {{promo.promoDescription}}. {{$productOrderCtrl.translations['antibody.pdp.commerceCard.promotion.learnmore']}}
产品信息
13466-1-AP
种属反应
已发表种属
宿主/亚型
分类
类型
抗原
偶联物
形式
浓度
规格
纯化类型
保存液
内含物
保存条件
运输条件
产品详细信息
Immunogen sequence: MAASLRLLG AASGLRYWSR RLRPAAGSFA AVCSRSVASK TPVGFIGLGN MGNPMAKNLM KHGYPLIIYD VFPDACKEFQ DAGEQVVSSP ADVAEKADRI ITMLPTSINA IEAYSGANGI LKKVKKGSLL IDSSTIDPAV SKELAKEVEK MGAVFMDAPV SGGVGAARSG NLTFMVGGVE DEFAAAQELL GCMGSNVVYC GAVGTGQAAK ICNNMLLAIS MIGTAEAMNL GIRLGLDPKL LAKILNMSSG RCWSSDTYNP VPGVMDGVPS ANNYQGGFGT TLMAKDLGLA QDSATSTKSP ILLGSLAHQI YRMMCAKGYS KKDFSSVFQF LREEETF (1-336 aa encoded by BC032324)
靶标信息
3-hydroxyisobutyrate dehydrogenase (3-hydroxy-2-methylpropanoate:NAD(+) oxidoreductase, EC 1.1. 1.31) is a dimeric mitochondrial enzyme that catalyzes the NAD(+)-dependent, reversible oxidation of 3-hydroxyisobutyrate, an intermediate of valine catabolism, to methylmalonate semialdehyde.
仅用于科研。不用于诊断过程。未经明确授权不得转售。
生物信息学
蛋白别名: 3'-hydroxyisobutyrate dehydrogenase; 3-hydroxyisobutyrate dehydrogenase, mitochondrial; epididymis secretory sperm binding protein; HCV NS5A-transactivated protein 1; HIBADH; unnamed protein product
基因别名: 6430402H10Rik; AI265272; HIBADH; NS5ATP1
UniProt ID: (Human) P31937, (Mouse) Q99L13, (Rat) P29266
Entrez Gene ID: (Human) 11112, (Mouse) 58875, (Rat) 63938